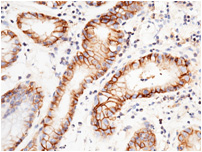

| 提供商 | 北京义翘神州科技股份有限公司 |
| 服务名称 | 兔单克隆抗体制备服务 |
| 服务步骤 | 具体内容 | 周期 | 交付内容 | 交付标准 |
| 抗原制备 | 详情请参阅抗原制备服务相关内容 | |||
| 抗原复核 | UV及SDS-PAGE分析 | 1-2天 | • 阳性克隆的抗体重链及轻链序列 • 纯化抗体 • 分别含有抗体重链、轻链的商业表达载体 • 实验报告 | 在ELISA检测中, 纯化抗体与免疫原结合 |
| 免疫及血清效价检测 | • 免疫前采血 • 2只兔子免疫 • 血清效价检测 • 最终采血 | 8-10周 | ||
| 建库及筛选 | 4-6周 | |||
| 抗体生产及纯化 | • 载体构建 • HEK293 细胞瞬转表达 • 蛋白A纯化抗体 | 2-3周 | ||
| QC分析 | • SDS-PAGE及UV分析 • ELISA检测 | 1-3天 | ||
• Human stomach Fig 1. Immunochemical staining of human target E with rabbit mAb. The image showing membrane staining of epithelium cell. | • Human rectal cancer Fig 2. Immunochemical staining of human target E with rabbit mAb. The image showing membrane staining of epithelium cell in intestinal gland. |
• Human placenta Fig 3. Immunochemical staining of human target E with rabbit mAb. The image showing positive staining of trophoblast. | • Human liver Fig 4. Immunochemical staining of human target E with rabbit mAb. The image showing membrane staining of hepatocyte. |
• Human gastric cancer Fig 5. Immunochemical staining of human target E with rabbit mAb. The image showing membrane staining of epithelium cell. | • Human esophagus Fig 6. Immunochemical staining of human target E with rabbit mAb. The image showing membrane staining of squamous epithelium cell. The left panel: tissue incubated with primary antibody; The right panel: tissue incubated with the mixture of primary antibody and antigen. |
 Fig 1. Immunofluorescence staining of target E in monkey stomach with rabbit mAb. The image showing membrane staining of gastric gland cell. The right panel: merge with DAPI. |  Fig 2. Immunofluorescence staining of human target E in HeLa cells with rabbit mAb. The image showing membrane staining of HeLa cells. |
 Fig 3. Lane A: A431 Whole Cell Lysate. Anti-target E rabbit mAb; Goat Anti-Rabbit IgG H&L (Dylight800). |  Fig 4. Analysis of anti-target E reactivity on HeLa cells. |

